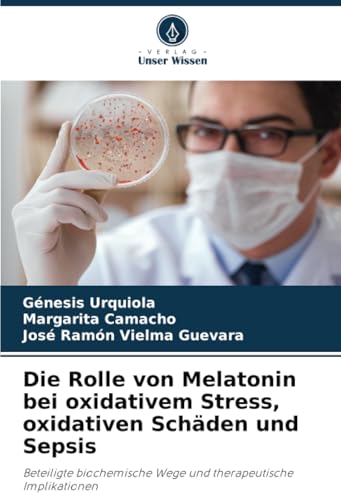

Annons
Melatonin
Annons
Annons









Sov dig till ett bättre liv : Vad andning, sex, melatonin, tyngdtäcke, fullmåne och kiwi kan göra för din sömn
Svenska, Inbunden, Pappersböcker, Familj, Hälsa & Livsstil
fr.
249 kr





799 kr
hos Naturkompaniet

799 kr
hos Naturkompaniet




799 kr
hos Naturkompaniet

799 kr
hos Naturkompaniet





799 kr
hos Naturkompaniet